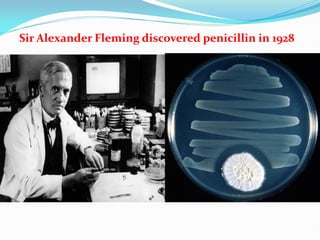
Sir Alexander Fleming discovered penicillin in 1928

The document provides a comprehensive overview of antimicrobial drugs, including their definitions, classifications, mechanisms of action, and issues related to bacterial resistance. It covers types of antibiotics like penicillins, cephalosporins, and glycopeptides, explaining their specific actions and therapeutic applications. Additionally, it discusses antimicrobial resistance, highlighting causes and mechanisms by which bacteria develop resistance to these drugs.